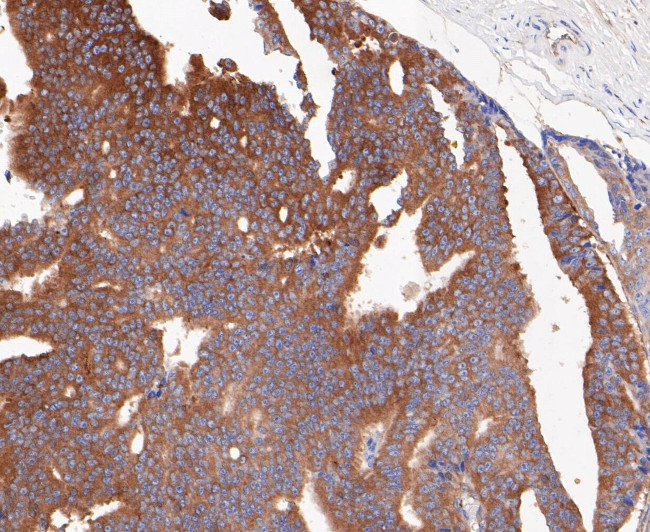
Lactoferrin Antibody in Immunohistochemistry (Paraffin) (IHC (P))

Search
Invitrogen
Lactoferrin Recombinant Rabbit Monoclonal Antibody (JE49-60)
{{$productOrderCtrl.translations['antibody.pdp.commerceCard.promotion.promotions']}}
{{$productOrderCtrl.translations['antibody.pdp.commerceCard.promotion.viewpromo']}}
{{$productOrderCtrl.translations['antibody.pdp.commerceCard.promotion.promocode']}}: {{promo.promoCode}} {{promo.promoTitle}} {{promo.promoDescription}}. {{$productOrderCtrl.translations['antibody.pdp.commerceCard.promotion.learnmore']}}
图: 1 / 3
Lactoferrin Antibody (MA5-34869) in IHC (P)



Please note: We are reviewing Western blot images included in the antibody testing data in our catalog, including those provided by third parties. Unless expressly labeled or annotated as “raw-unedited”, Western blot images included in the antibody testing data in our catalog may have been edited, optimized or otherwise adjusted for presentation.
产品信息
MA5-34869
种属反应
宿主/亚型
Expression System
分类
类型
克隆号
抗原
偶联物
形式
浓度
规格
纯化类型
保存液
内含物
保存条件
运输条件
RRID
产品详细信息
Positive Control: Human spleen tissue, human prostate cancer tissue.
靶标信息
Lactoferrin (LF) is an iron binding glycoprotein. LF consists of a single polypeptide chain (approximately 80 kDa) folded into two structurally homologous lobes, each of which can reversibly bind one ferric ion (Fe3+). LF is found in external fluids, including milk and mucosal secretions, and is a prominent component of secondary granuals of neutrophils. The protein demonstrates a broad spectrum of properties, including regulation of iron homeostasis, host defense against a broad range of microbial infections, anti-inflammatory activity, regulation of cellular growth and differentiation and protection against cancer development and metastasis. LTF acts as a major first line defense against microbial infections, partly due to its ability to efficiently bind to and hence remove Fe3+ from the environment, but studies have also shown that LTF possesses bactericidal properties and proteolytic activity, capable of cleaving arginine-rich sequences within microbial proteins. Three isoforms of LTF have been identified: LTF-alpha, LTF-beta and LTF-gamma and receptors for LTF are expressed in the gastrointestinal tract, by macrophages, lymphocytes, neutrophils and platelets and also by some bacteria.
仅用于科研。不用于诊断过程。未经明确授权不得转售。
篇参考文献 (0)
生物信息学
蛋白别名: CKRX; Growth-inhibiting protein 12; Kaliocin 1; Kaliocin1; Lactoferricin H; Lactoferrin; LactoferroxinA; LactoferroxinB; LactoferroxinC; Lactotransferrin; Lfcin H; LfcinH; Talalactoferrin
基因别名: GIG12; LF; LTF
Entrez Gene ID: (Human) 4057